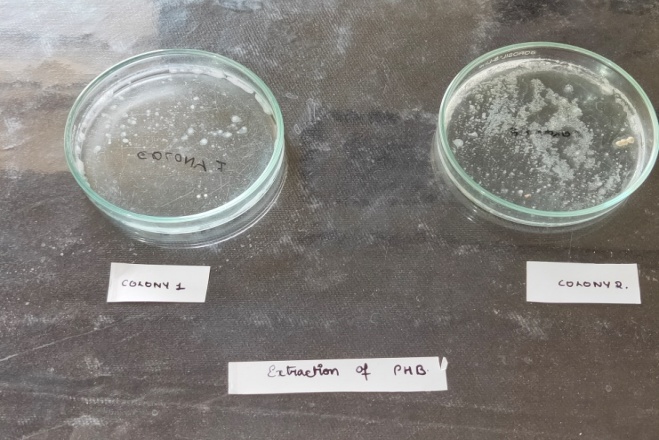

Department of Biochemistry, St. Francis College for Women, Hyderabad, Telangana, India 500016
Email: dipalikumari1410@gmail.com
Received: 10 Jul 2020, Revised and Accepted: 08 Sep 2020
ABSTRACT
Objective: Environmental concerns have prompted research into the development of biodegradable polymer as an alternative to petroleum-based plastics. Polyhydroxybutyrates (PHBs) are good alternatives to produce biodegradable plastics. Some bacteria are found to be producing PHB. The aim of this work was to isolate potential PHB producing bacteria and screen them for their ability to produce PHB.
Methods: Contaminated water sample from Gopalpur beach, Bhubaneswar was the source of bacteria. Three colonies were isolated from the water sample. The samples were named as C1, C2 and C3. The colonies were first identified by colony morphology. The sudan black screening test was done to screen for the production of (PHB) polyhydroxy butyrate by bacterial isolates.
Results: The bacterial isolates C1 and C2 showed a positive result for the production of polyhydroxy butyrate (PHB). Presence of PHB granules in Cocobacillus and Rod shaped bacillus was confirmed.
Conclusion: Polyhydroxybutyrate (PHB), a kind of microbial polyester that accumulates as a carbon/energy reserve material in various microorganisms, was thus concluded to be a decent alternative for plastics. Because of their special characteristics and broad biological applications, biodegradable plastics are compounds with a promising future.
Keywords: Bacteria, Biochemical tests, Bioplastic, Biodegradable, Polyhydroxybutyrate
© 2020 The Authors. Published by Innovare Academic Sciences Pvt Ltd. This is an open access article under the CC BY license (http://creativecommons.org/licenses/by/4.0/)
DOI: http://dx.doi.org/10.22159/ijcpr.2020v12i6.40279. Journal homepage: https://innovareacademics.in/journals/index.php/ijcpr
Plastic materials generated from petrochemicals are non-biodegradable and impose environmental hazards. Synthetically generated polymers are cheap and cost-effective, but their prevalence has a consequential environmental impact. There is an alarming rise in petroleum prices and environmental impacts associated with the products, with the depletion of fossil fuels [1]. There is a need to study and to develop new biodegradable polymers with plastic-like properties [1, 2]. Polyhydroxybutyrate (PHB) is a linear polymer of D-3-hydroxyl butyrate and best known of the polymers related to polyhydroxyalkanoates that is produced by several microorganisms as an energy source [3, 4]. Biodegradable plastics offer ‘eco-friendly’ perspectives in nature, protecting the environment from hazards caused by conventional petroleum-based plastics [5]. Owing to different degrees of biodegradability, there are thus many varieties of biodegradable plastics. Among them, polyhydroxybutyrate (PHBs) are the only 100% biodegradable ones (can be degraded aerobically or anaerobically by oil microorganisms). They are polymers possessing properties similar to various synthetic thermoplastic like polypropylene [4, 6, 7]. This makes them useful for a wide range of applications, enabling commercial production of biodegradable plastics in the future which can replace plastic materials currently obtained from petroleum bases [1]. PHB based plastics made by combining PHB with other biocompatible polymers (like 3-hydroxy valerate) find many applications in agriculture, packaging, and medical field, including drug delivery and tissue engineering. Despite these interesting properties, the industrial production of PHB remains not well established owing to its high production cost. This high costing has made it unable to compete with conventional cost-effective plastics in the commercial market [8]. The PHB content and its composition are influenced mainly by the strain of the microorganism, the type of substrate employed and its concentration, and other growth conditions such as pH, time and temperature [8]. This study emphasises on isolation and characterization of PHB producing bacteria from easily accessible source i.e., contaminated water samples.

Fig. 1: Pathway of polyhydroxybutyrate (PHB) biosynthesis
At the beginning, the reversible condensation of two molecules of acetyl-CoA, by the action of the 3-ketothiolase, produces the Acetyl-CoA into R-(-)-3-hydroxybutyrate-CoA. The reductase enzyme is NADPH-linked and finally, R-(-)-3-hydroxybutyrate-CoA is polymerized to form PHB under the action of PHA synthase [5, 7]. Many beneficial properties of PHB have been found through studies done by researchers. They have: Good oxygen permeability, good ultra-violet resistance but poor resistance to acids and bases, soluble in chloroform and other chlorinated hydrocarbons [9], biocompatible and hence is suitable for medical applications [10], melting point 175 °C and glass transition temperature 2 °C, tensile strength 40 MPa, close to that of polypropylene, sinks in water (while polypropylene floats), facilitating its anaerobic biodegradation in sediments. Nontoxic, less 'sticky' when melted, water-insoluble and relatively resistant to hydrolytic degradation. This property distinguishes PHB from most of the presently available biodegradable plastics, which are either water-soluble or moisture-sensitive.
This project was done in St. Francis College for Women, Hyderabad in collaboration with Nitza Biologicals Institute in the month of May, 2019 as an undergraduate project. Water sample was collected from the contaminated water of Gopalpur beach, Bhubaneswar, because of the approachability and requirement of seawater. Samples were serially diluted and inoculated/spread plated on a sterile nutrient agar plate (peptone-5 gm, sodium chloride-5 gm, beef extract-3 gm, agar-18 gm, distilled water-1000 ml). The plated were then kept for incubation for 24 h at 37 °C. Colonies showing specific features were picked and purified by recurrent streaking on similar agar plates. The purified colonies were conserved on nutrient agar slants.
Qualitative testing was done for all the bacterial isolates to check for PHB production following the viable colony method of screening using sudan black dye [1, 8]. After staining with sudan black, bacteria containing PHAs exhibit dark granules. The bacterial colonies were isolated and streak plated on nutrient agar media with 1% glucose and kept for incubation at 37 °C for 24 h. Then the ethanolic solution containing 0.02% Sudan black was spread over the petri plate containing colonies and was kept undisturbed for 30 min. They were washed with 96% ethanol to remove excess stain from the colonies.
The different bacterial isolates that gave positive results to the PHB production were then identified by staining and different biochemical tests based on Bergey’s Manual of Determinative Bacteriology. Various staining procedures such as gram staining, endospore staining and different biochemical tests were done.
Production of polyhydroxy-butyrate
Two production media were prepared for the production of PHB. First media had modified nutrient broth (peptone-5 gm, sodium was chloride-5 gm, beef extract-3 gm, distilled water-1000 ml) with 1% glucose [8, 11].
The second media was a Minimal Salt Media (MSM) (KH2PO4-1.5 gm, Na2HPO4.2H2O-1.5 gm, NaCl-1.0 gm, (NH4)2SO4–2.0 gm, MgSO4-0.2 gm, CaCl2. 2H2O–0.02 gm, NH4Fe(III) citrate–0.05 gm, trace element solution*-1 ml/l, glucose-10 gm/l) (Trace element solution-ZnSO4.7H2O-100 mg/l, H3PO4-300 mg/l, CoCl2-200 mg/l, CuSO4–6 mg/l, NiCl2-20 mg/l, Na2MoO4–30 mg/l, M2Cl2-25 mg/l, the trace element solutions was prepared separately, autoclaved and mixed with the media[1])
The bacterial isolates showing positive in the screening for the polyhydroxybutyrate were then incubated into the production media and were then kept for 72 h at 37 °C.
Extraction of polyhydroxy butyrate
The culture was then collected and centrifuged at 8000 rpm for 15 min at 4 °C. The supernatant was discarded and the pellet was treated with 10 ml sodium hypochlorite and incubated at 30 °C for 2 h. After incubation, the mixture was centrifuged at 8000rpm for 10 min at 4 °C and washed sequentially with distilled water, acetone and alcohol. Finally the residue was extracted with boiling chloroform and poured in a sterile glass petri plate for evaporation of chloroform. After all the chloroform is evaporated, the extract is stored in 20 °C for further analysis.
Estimation of PHB produced-colorimetric estimation
The UV absorption spectrum of PHB was analysed after its conversion to crotonic acid by treating it with conc. H2SO4. The development of brown colour in the solution due to crotonic acid formation was significantly used to determine the concentration counting on the intensity of the colour [11]. Sample was moved into a clean test tube and 10 ml of concentrated H2SO4 was added to test tubes and capped. The capped test tubes were heated for 10 min at 100 °C in a water bath. After that, the solution was allowed to cool and mixed thoroughly. Sample was transferred to silica cuvette to read the absorbance at 445 nm. The absorbance was measured against sulphuric acid as blank [11].
The plates were incubated for 24 h after spread plating of water sample. Three colonies were isolated from the water sample. The samples were named as C1, C2 and C3. The colonies were first identified by colony morphology. The sudan black screening test is done to screen for the production of (PHB) poly hydroxyl butyrate by bacterial isolates. The bacterial isolates C1 and C2 has shown a positive result for the biochemical tests (table 1 and fig. 2), gram staining and endospore staining (table 2 and fig. 3) and production of poly hydroxybutyrate (PHB) fig. 4.
Table 1: Biochemical tests and their observations
| Biochemical tests | Objective | Observations |
| C 1 | ||
| Starch hydrolysis | To differentiate organism based on their α-amylase enzyme activity (hydrolysis of starch). | +ve |
| Catalase test | For differentiating aerobic and obligate anaerobic bacteria. |
+ve |
| Simmons test | It is used for the differentiation of Gram-negative bacteria on the basis of citrate utilization. | +ve |
| Voges proskauer test | The Voges-Proskauer (VP) test is used to determine if an organism produces acetylmethyl carbinol from glucose fermentation. | +ve |
Mannitol fermentation test |
The purpose is to see if the microbe can ferment the carbohydrate (sugar) mannitol as a carbon source. |
+ve |
Table 2: Gram staining and endospore staining results
| Sample | Gram staining | Morphology | Endospore staining |
| Colony 1 | +ve | Coccobacillus | +ve |
| Colony 2 | +ve | Rod shaped chained bacillus | +ve |
Table 3: Table for colorimetric estimation
| Sample | Colony | Absorbance |
| Water (marine) sample | C1 | 0.20 |
| Water (marine) sample | C2 | 0.22 |

Fig. 2: Observations of biochemical tests

Fig. 3: Observations of gram staining and endospore staining
Fig. 4: Extracted PHB molecules
Polyhydroxybutyrate (PHB), accumulates as a carbon/energy reserve material in various microorganisms and is a type of microbial polyester can prove to be a decent alternative to plastics derived from petroleum [10]. In the present study, 3 bacterial strains were screened for PHB production. Three colonies were isolated from the water sample. The samples were named as C1, C2 and C3. The colonies were identified for colony morphology and biochemical tests along with gram staining and endospore staining were done. The results were positive for biochemical tests (table 2 and fig. 2) in C1 and C2. These two samples ie; C1 and C2 showed positive results for gram staining and endospore staining as well (table 3 and fig. 3). Based on these observations it was concluded that C1 and C2 samples were of Cocobacillus and Rod shaped bacillus respectively. These conclusions were derived in accordance with the studies done earlier [7, 8].
Two production media-modified nutrient broth media and minimal salt media was prepared for production of PHB. C1 and C2 samples showed positive results in the screening for the polyhydroxybutyrate and were therefore incubated into the production media for PHB production (fig. 4). PHB thus produced was extracted and processed for colorimetric estimation at 445 nm and absorbance was read (table 4). Presence of PHB granules in Cocobacillus (Colony C1) and Rod shaped bacillus (Colony C2) was confirmed with bacillus showing more concentration of PHB formation (absorbance 0.22)
Based on the observations and results of our study it was understood that many other bioplastics with different structures, properties and applications could be obtained if the appropriate organism were selected and genetically manipulated [1, 6]. However, the primary problem for large-scale production and commercialization of PHB is their high assembly cost as compared to plastics derived from petrochemicals. Lately, many attempts has been committed to scale back the assembly cost of PHB by using techniques such as; developing efficient bacterial strains, enhancing fermentation and recovery processes. Most reports regarding the manufacture of PHB suggested that, the main contributor to the general PHB production cost was due to carbon substrate cost [1]. As such, the selection of efficient carbon substrate is a key aspect, which defines the total cost of the final product. The alternative approach is to look for renewable, economically achievable and easily available carbon substrates for microbial growths and therefore efficient PHB production [1]. Because of their special characteristics and broad biotechnological applications, bioplastics are compounds with promising future [12].
The studied bacillus sps. Rod shaped bacillus were found to be more efficient in production of PHB in comparison to Cocobacillus. Bioplastics which are biodegradable and have many beneficial properties compared to petroleum derived plastics are the need of time due to environmental concerns. Further studies can be done with more resources for better results. Bacteria from different sources and different species can be isolated and studied for their capabilities to produce more amount of PHB for commercial benefits.
I would like to express my special gratitude to my mentor and teachers from Department of Biochemistry, St. Francis College for Women, Begumpet, Mr. Debasish Sahoo and Mr. Virendra Vaishnav, Sr. Research associates, Nitza bioventure, Hyderabad; for their guidance and support in completing my project and this research paper. I would also like to extend my gratitude to the Principal Sr. Sandra Horta, St. Francis College for Women, Begumpet for providing me with all the facilities that was required.
Nil
All the authors have contributed equally.
Declared none
Anteneh Getachew, Fantahun Woldesenbet. Production of biodegradable plastic by polyhydroxybutyrate (PHB) accumulating bacteria using low cost agricultural waste material. BMC Res 2016. DOI:10.1186/s13104-016-2321-y.
BrandI H, Richard A Gross, Robert W Lenz, R Clinton Fuller. Plastics from bacteria and for bacteria: poly(β-hydroxyalkanoates) as natural, biocompatible, and biodegradable polyesters from. Adv Biochem Eng Biotechnol 1990;41:77-93.
Anon Thammasittirong, Sudarat Saechow, Sutticha Na-Ranong Thammasittirong. Efficient polyhydroxybutyrate production from Bacillus juice substrate thuringiensis using sugarcane. Turk J Biol 2017;41:992–1002.
Alyaa Hamieh, Zakia Olama, Hanafi Holail. Microbial production of polyhydroxybutyrate, biodegradable plastic using agro-industrial waste products. Global Adv Res J Microbiol 2013;2:54-64.
Neha Sharma. PHB production by bacteria and it’s application as biodegradable plastic in various industries. Academic J Polymer Sci 2019;2:2641-8282.
C Pena, T Castillo, A Garcia, M Millan, D Segura. Biotechnological strategies to improve production of microbial poly-(3-hydroxybutyrate): a review of recent research work. Microbial Biotechnol 2014;7:278–93.
KR Shah. Optimization and production of polyhydroxybutarate(PHB) by bacillus subtilis G1S1 from soil. Int J Curr Microbiol Appl Sci 2014;3:377-87.
Christina Thapa, Pallavi Shakya, Rabina Shrestha, Sushovita Pal, Prakash Manandhar. Isolation of polyhydroxybutyrate (PHB) producing bacteria, optimization of culture conditions for PHB production, extraction and characterization of PHB. Nepal J Biotechnol 2018;6:62-8.
Jacquel Nicolas, Chi Wei Lo, Ho Shing Wu, Yu Hong Wei, Shaw S. Wang solubility of polyhydroxyalkanoates by experiment and thermodynamic correlations. AIChE J 2007;53:2704-14.
Sabbir Ansari, Tasneem Fatma. Cyanobacterial polyhydroxybutyrate (PHB): screening, optimization and characterization. PLoS One 2016;11:e0158168.
Jikasmita Dalei, Debasish Sahoo, Aishna Sagar. Isolation, characterization of poly-hydroxy butyrate (PHB) producing bacteria from paddy soil and contaminated lake water and comparative study for productivity of PHB from different isolates. IJESR 2015;3:2347-6532.
Jose M Luengo, Belen Garcia, Angel Sandoval, German Naharro, Elias R Olivera. Bioplastics from microorganisms. Curr Opinion Microbiol 2003;6:251-60.